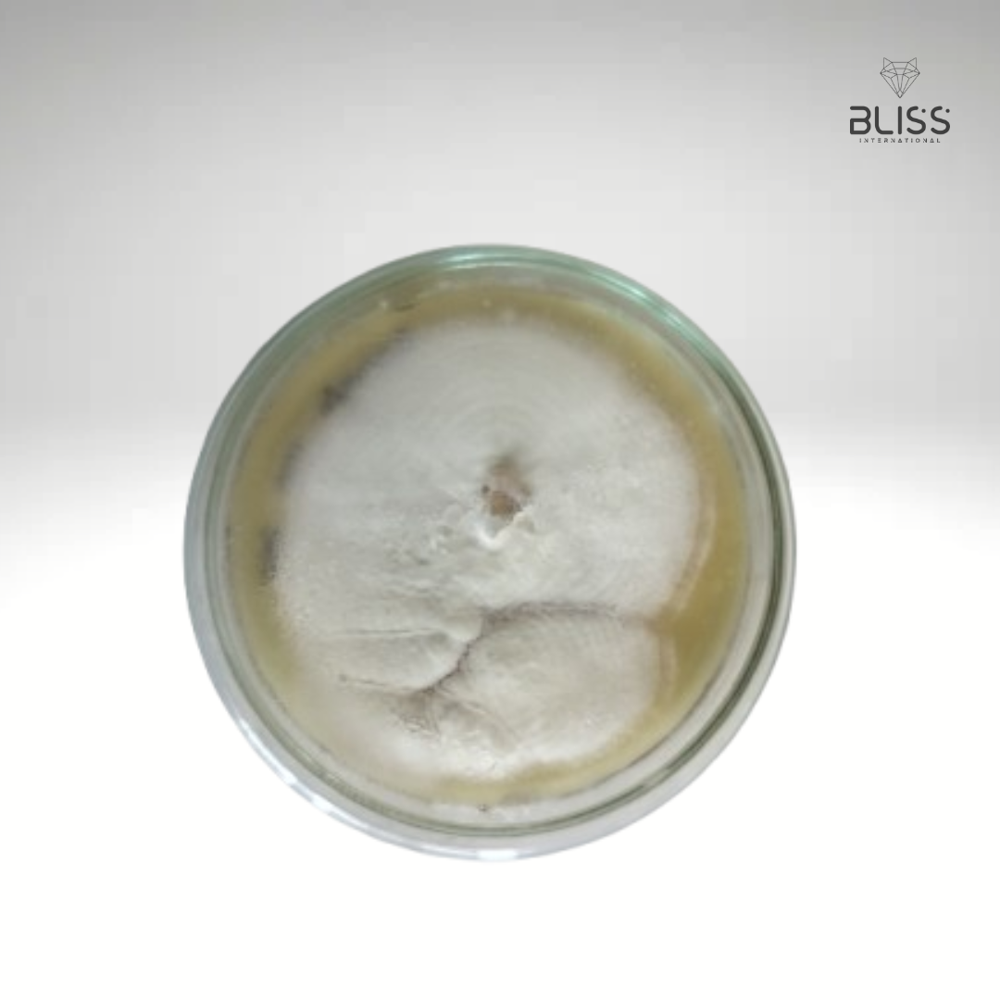
Beaveria Bassiana Technical - Color: White

Coal Based Powdered Activated Carbon - Application: Water Treatment
Price: 50 INR / Kilograms
Get Latest Price
Minimum Order Quantity :
1000 Kilograms
In Stock
Product Specifications
| Moisture (%) | <05% |
| Iodine Value | 400-700 |
| Purity(%) | 90 |
| Type | coal based |
| Application | Water Treatment |
| Form | Powder |
| Payment Terms | Cash Advance (CA), Cash in Advance (CID), Telegraphic Transfer (T/T) |
| Supply Ability | 5000 Per Week |
| Delivery Time | 1 Week |
| Sample Available | Yes |
| Sample Policy | Free samples available with shipping and taxes paid by the buyer |
| Packaging Details | 25 KG & 500 Kg Bag |
| Main Export Market(s) | Australia, Central America, South America, Eastern Europe, Western Europe, Middle East, Africa |
| Main Domestic Market | All India |
Company Details
At Bliss, we specialize in delivering sustainable solutions across two diverse sectors.
1. Activated Carbon Solutions: Providing premium activated carbon products for applications in water filtration, air purification, and industrial processes. Our offerings emphasize quality and eco-friendliness, meeting global standards to support a cleaner planet.
2. Agricultural Input Products: Innovating in sustainable Biofertilizers, Biopesticides, and Biostimulants to enhance crop productivity while preserving soil health. Our solutions empower farmers with environmentally friendly tools to maximize yields.
Business Type
Exporter, Supplier, Trading Company
Employee Count
2
Establishment
2024
Working Days
Monday To Sunday
GST NO
24EXCPP7212L1ZA
Payment Mode
Online Payments (NEFT/RTGS/IMPS), Cheque/DD, Cash
Related Products
Explore Related Categories
More Product From This seller
Seller Details
GST - 24EXCPP7212L1ZA
Ahmedabad, Gujarat
Proprietor
Mr Ankit Patel
Members since
1 Years
Address
B 1009, Empire Business Hub, Science City Road, Sola, Ahmedabad, Gujarat, 380060, India
powdered activated carbon in Ahmedabad
Report incorrect details